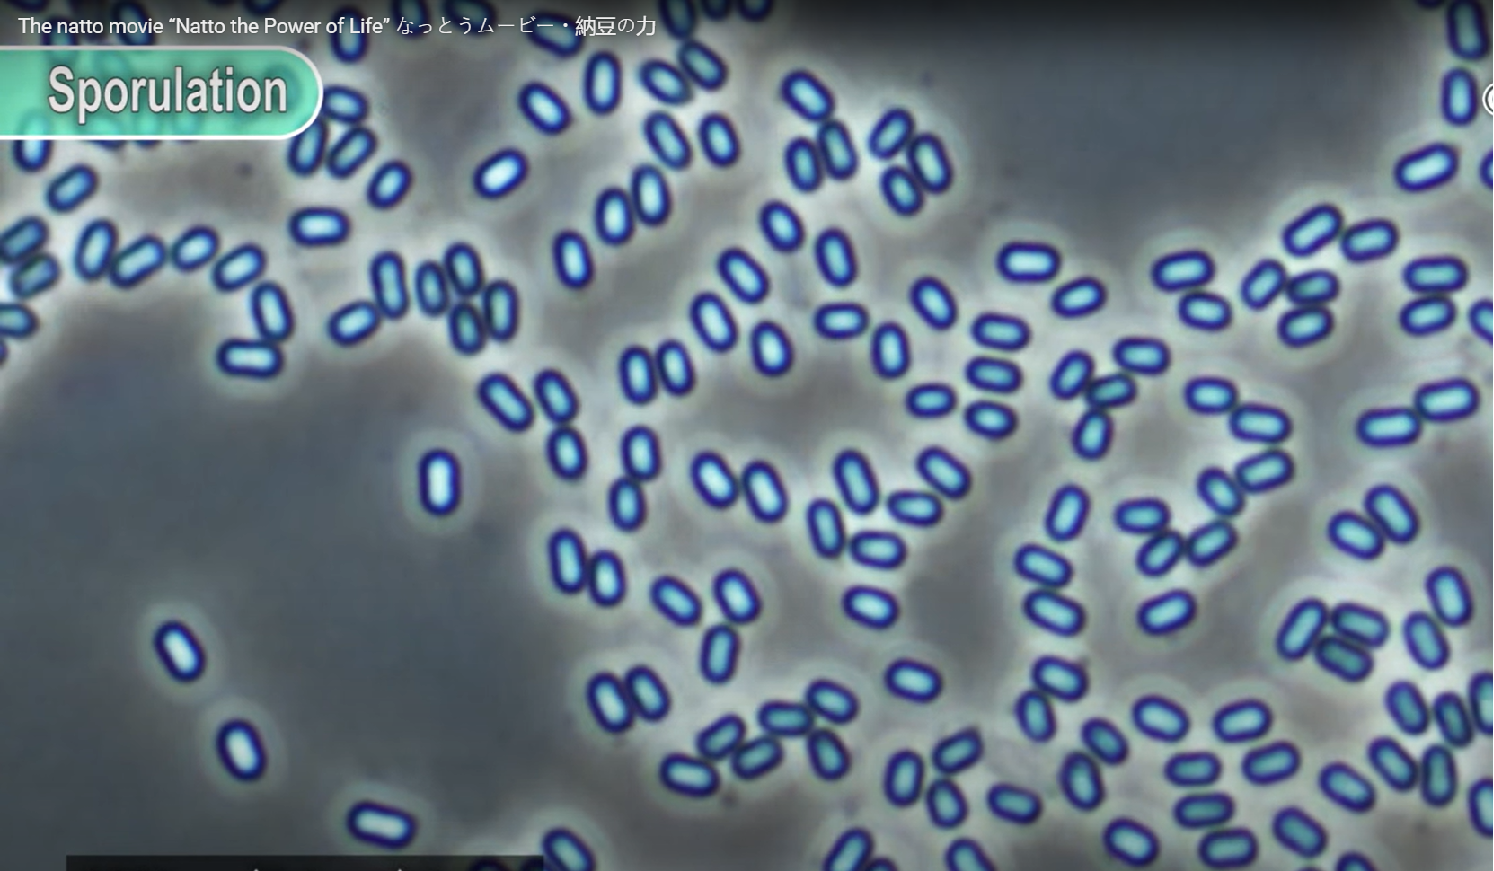
Vi sinh Bacillus Natto

BIO CLEAR-DC là chế phẩm vi sinh diệt khuẩn thế hệ mới được phát triển bởi Yanten Biotech (Đài Loan).
BIO CLEAR-DC là chế phẩm vi sinh diệt khuẩn thế hệ mới được nghiên cứu bởi Yanten Biotech (Đài Loan) và phân phối bởi Plasma Việt Nam, giúp kiểm soát mầm bệnh nguy hiểm như các nhóm vi khuẩn phổ biến Vibrio, Streptococcus, Aeromonas, từ đó giúp phòng ngừa các bệnh phổ biến trên tôm cá như EMS, TPD, phân trắng, lở loét.
Với hàm lượng vi sinh cao, kết hợp các chủng độc quyền cùng công nghệ sản xuất tiên tiến, BIO CLEAR-DC mang lại giải pháp sinh học bền vững – an toàn – không tồn dư, phù hợp cho mô hình nuôi thâm canh, siêu thâm canh suốt vụ nuôi.
1. Vi sinh diệt khuẩn là gì và vì sao ngày càng quan trọng?
Trong các hệ thống nuôi thâm canh, môi trường nước thường chứa lượng lớn chất hữu cơ, khí độc và mầm bệnh. Các biện pháp xử lý nước truyền thống như lắng – lọc – diệt khuẩn hóa chất chỉ cải thiện được phần ngọn: làm trong và sạch nước tức thời nhưng không giúp kiểm soát được vi khuẩn gây bệnh một cách ổn định lâu dài.
Vi sinh diệt khuẩn là nhóm lợi khuẩn có khả năng ức chế – cạnh tranh – vô hiệu hóa vi khuẩn gây hại, giữ cho hệ vi sinh ao nuôi cân bằng và bền vững. Khác với hóa chất diệt khuẩn, giải pháp này không gây tồn dư, không làm sốc tôm, cá và phù hợp cho việc sử dụng suốt vụ nuôi.
Vi sinh Bacillus Natto – vi sinh có lợi thường thấy trong chế phẩm vi sinh. Nguồn: Maurice Zwart-Microbiology Bacterialist.
2. Vai trò của vi sinh diệt khuẩn trong phòng bệnh thủy sản
Các nhóm vi khuẩn có hại như Vibrio, Streptococcus, Aeromonas là những nguyên nhân chủ yếu gây ra:
- Hội chứng bệnh phân trắng (WFS),
- Hội chứng tôm chết sớm/hoại tử gan tụy cấp tính (EMS/AHPNS),
- Bệnh mờ đục hậu ấu trùng (TPD),
- Các bệnh lở loét, xuất huyết, đốm đỏ, gan thận mủ…. trên cá – ếch – lươn.
Vi sinh diệt khuẩn giúp hạn chế chúng bằng cách:
- Tiết enzyme và hợp chất kháng khuẩn tự nhiên để ức chế vi khuẩn,
- Chiếm chỗ bám và dinh dưỡng,
- Tạo môi trường nước ổn định, ít biến động.
Nhờ đó, người nuôi giảm phụ thuộc hóa chất, kiểm soát bệnh bằng sinh học – đúng xu hướng bền vững.
3. BIO CLEAR-DC – giải pháp vi sinh diệt khuẩn chuyên dụng cho ao nuôi
BIO CLEAR-DC được Yanten Biotech phát triển dành riêng cho môi trường nuôi mật độ cao. Sản phẩm được Plasma Việt Nam nhập khẩu chính thức, mang đến giải pháp kiểm soát mầm bệnh chủ động, giảm nguy cơ bùng phát các bệnh nguy hiểm.
4. Thành phần probiotic chủ lực và công nghệ sản xuất chuyên biệt
BIO CLEAR-DC chứa các chủng vi sinh hiệu quả cao thuộc nhóm Bacillus và Lactobacillus, với các chủng độc quyền gồm:
Bacillus Subtilis YT1: Kháng – kìm khuẩn mạnh, tăng tiêu hóa và giúp duy trì hoạt tính sinh học lâu dài.
Bacillus Pumilus D5: Đối kháng phổ rộng, ức chế hiệu quả nhóm Vibrio và các vi khuẩn gây bệnh khác. Sản sinh nhiều hợp chất kháng khuẩn tự nhiên (bacteriocin, pumila cidin,..) để tiêu diệt mầm bệnh.
Bacillus Natto: Giảm độ nhớt nước – phân hủy nhớt bạt, và mùi hôi nước ao. Ức chế sinh khí độc và vi khuẩn gây bệnh. Tăng khả năng phân hủy thức ăn dư thừa, chất thải hữu cơ.
Hàm lượng vi sinh đậm đặc ≥ 5 × 10⁹ CFU/g. Dạng bột hòa tan nhanh trong nước, giúp vi sinh phân tán và hoạt động ngay khi sử dụng.
5. Cơ chế tác động và hiệu quả trong ao
BIO CLEAR-DC hoạt động theo các cơ chế:
Tiết enzyme và các chất kháng sinh tự nhiên
Các chủng vi sinh trong BIO CLEAR-DC tiết ra nhiều loại enzyme, phân hủy nhanh chất hữu cơ và các hợp chất kháng sinh tự nhiên giúp ức chế vi khuẩn gây bệnh trong môi trường ao.
Cạnh tranh dinh dưỡng và vị trí bám với vi khuẩn gây bệnh
Vi sinh có lợi sử dụng hết nguồn dinh dưỡng và chiếm trước các vị trí bám trong nước và đáy ao.
Khi thiếu dinh dưỡng và không còn bề mặt để bám, các nhóm vi khuẩn gây bệnh (Vibrio, Aeromonas, Streptococcus) không thể phát triển mạnh, từ đó mật độ mầm bệnh giảm rõ rệt.
Tạo “Clear Zone” – vùng an toàn ức chế mầm bệnh
Khi mật độ vi sinh có lợi tăng lên, chúng hình thành một vùng “Clear Zone” quanh khu vực sinh sống.
Vùng này chứa enzyme, acid hữu cơ và kháng sinh tự nhiên giúp ngăn chặn sự xâm nhập và phát triển của vi khuẩn gây bệnh, tạo môi trường nước sạch và ổn định hơn.
Từ đó mang lại các hiệu quả rõ rệt:
- Hạn chế Vibrio, Streptococcus, Aeromonas.
- Giảm EMS, TPD, phân trắng ở tôm.
- Giảm lở loét – đốm đỏ – xuất huyết trên cá.
- Tăng sức đề kháng và tỷ lệ sống.
- Giữ nước sạch sâu và ổn định lâu dài.
6. Hiệu quả được chứng minh qua thử nghiệm
Kết quả thử nghiệm Clear Zone do Yanten Biotech thực hiện cho thấy BIO CLEAR-DC sở hữu khả năng ức chế mạnh mẽ nhiều tác nhân gây bệnh quan trọng trong ao nuôi tôm cá. Ở thử nghiệm thứ nhất, sản phẩm tạo vòng ức chế rõ rệt đối với Vibrio parahaemolyticus (4.0 mm), Aeromonas hydrophila (4.0 mm), Edwardsiella tarda (6.0 mm) và đặc biệt là Nocardia seriolae – đạt mức ức chế lên đến 13.0 mm. Các chủng Streptococcus iniae và Lactococcus garvieae cũng bị ức chế mạnh với đường kính lần lượt 11.0 mm và 8.0 mm.

Ở thử nghiệm thứ hai, BIO CLEAR-DC tiếp tục chứng minh khả năng kiểm soát các loài Vibrio gây hại hàng đầu, bao gồm Vibrio harveyi (5.0 mm), Vibrio vulnificus (3.0 mm), Vibrio cholerae (4.0 mm) và Vibrio parahaemolyticus (3.0 mm). Bên cạnh đó, sản phẩm cũng tạo vòng ức chế ổn định đối với Escherichia coli và Salmonella typhimurium.

Những kết quả này khẳng định rằng BIO CLEAR-DC không chỉ có khả năng đối kháng vi khuẩn phổ rộng, mà còn đặc biệt hiệu quả trong việc kiểm soát nhóm Vibrio – tác nhân gây EMS/AHPNS, phân trắng và nhiều bệnh nguy hiểm trên tôm. Đây là bằng chứng mạnh mẽ về hiệu quả diệt khuẩn sinh học của sản phẩm, tạo nền tảng quan trọng cho phòng bệnh chủ động trong mô hình nuôi thâm canh.
7. Yanten Biotech – nền tảng công nghệ phía sau BIO CLEAR-DC
Yanten Biotech thành lập năm 1970 tại Chiayi – Đài Loan, sở hữu:
- Trên 50 năm kinh nghiệm trong lĩnh vực công nghệ vi sinh.
- 3 nhà máy đạt chuẩn tại Đài Loan, Trung Quốc, Malaysia.
- Đội ngũ R&D chuyên sâu gồm 5 Tiến sĩ và 4 Thạc sĩ.
- Hơn 100 nhân sự trên toàn cầu.
Sản phẩm của Yanten được ứng dụng rộng rãi tại nhiều thị trường châu Á.

Yanten Biotech – Đơn vị sản xuất vi sinh hàng đầu thế giới với 55 kinh nghiệm.
8. Hướng dẫn sử dụng BIO CLEAR-DC
Sản phẩm phát huy hiệu quả tối ưu khi được sử dụng đúng liều, đúng thời điểm và trong điều kiện môi trường phù hợp. Người nuôi có thể tham khảo hướng dẫn dưới đây để đảm bảo BIO CLEAR-DC đạt hiệu quả cao nhất trong ao nuôi.
BIO CLEAR-DC được đóng gói dạng bột 500g, thích hợp cho nhiều mô hình nuôi khác nhau. Liều khuyến nghị cho ao nuôi có độ sâu 1,5 – 2m là 500g cho mỗi 2.500 – 3.500m² mặt nước, sử dụng định kỳ 15 – 20 ngày một lần nhằm duy trì mật độ vi sinh có lợi và kiểm soát mầm bệnh ổn định. Hoặc rút ngắn chu kỳ tuỳ theo chất lượng ước ao.
Khi sử dụng, hòa tan sản phẩm với 150 – 200 lít nước ao, khuấy đều và ủ trong 30 – 60 phút để kích hoạt vi sinh. Sau đó tạt đều khắp ao vào thời điểm mát trong ngày để đảm bảo hoạt tính vi sinh đạt mức tối đa.
Lưu ý quan trọng:
- Không dùng BIO CLEAR-DC đồng thời với các sản phẩm có tính diệt khuẩn mạnh nhằm tránh làm giảm hiệu lực của vi sinh.
- Nên sử dụng ngay từ đầu vụ để đảm bảo duy trì chất lượng nước ao tốt suốt vụ nuôi.

BIO CLEAR DC – Sử dụng đúng giúp mang lại hiệu quả xử lý nước vượt trội.
9. Kết luận
BIO CLEAR-DC là giải pháp diệt khuẩn sinh học hiệu quả, an toàn và phù hợp xu hướng nuôi bền vững. Với nền tảng công nghệ probiotic tiên tiến từ Yanten Biotech (Đài Loan) và được phân phối chính thức bởi Plasma Việt Nam, sản phẩm giúp người nuôi kiểm soát chủ động mầm bệnh, ổn định môi trường nước và bảo vệ sức khỏe tôm cá suốt vụ nuôi.
Liên hệ Plasma Việt Nam ngay để được tư vấn chi tiết và nhận chiết khấu hấp dẫn!
- Hotline: 0949 002 700
- Fanpage: Plasma Thủy sản
- Website:plasmachem.vn







![[TUYỂN DỤNG] CHUYÊN VIÊN TƯ VẤN KỸ THUẬT THỦY SẢN](https://plasmachem.vn/wp-content/uploads/2025/10/1200x800-03-scaled-246x185.jpg)




![[TUYỂN DỤNG] CHUYÊN VIÊN TƯ VẤN KỸ THUẬT THỦY SẢN](https://plasmachem.vn/wp-content/uploads/2025/10/1200x800-03-scaled-140x93.jpg)